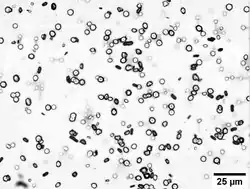

Xylan


Xylan (/ˈzaɪlæn/;[3] /ˈzaɪlən/[4]) (CAS number: 9014-63-5) is a type of hemicellulose, a polysaccharide consisting mainly of xylose residues. It is found in plants, in the secondary cell walls of dicots and all cell walls of grasses.[5] Xylan is the third most abundant polysaccharide on Earth, after cellulose and chitin.
Composition
Xylans are polysaccharides made up of β-1,4-linked xylose (a pentose sugar) residues with side branches of α-arabinofuranose and/or α-glucuronic acids. On the basis of substituted groups xylan can be categorized into three classes i) glucuronoxylan (GX) ii) neutral arabinoxylan (AX) and iii) glucuronoarabinoxylan (GAX).[6] In some cases contribute to cross-linking of cellulose microfibrils and lignin through ferulic acid residues.[7]
Occurrence
Plant cell structure
Xylans play an important role in the integrity of the plant cell wall and increase cell wall recalcitrance to enzymatic digestion;[8][9] thus, they help plants to defend against herbivores and pathogens (biotic stress). Xylan also plays a significant role in plant growth and development. Typically, xylans content in hardwoods is 10-35%, whereas they are 10-15% in softwoods. The main xylan component in hardwoods is O-acetyl-4-O-methylglucuronoxylan, whereas arabino-4-O-methylglucuronoxylans are a major component in softwoods. In general, softwood xylans differ from hardwood xylans by the lack of acetyl groups and the presence of arabinose units linked by α-(1,3)-glycosidic bonds to the xylan backbone.[10]
Algae
Some macrophytic green algae contain xylan (specifically homoxylan[11]) especially those within the Codium and Bryopsis genera[12] where it replaces cellulose in the cell wall matrix. Similarly, it replaces the inner fibrillar cell-wall layer of cellulose in some red algae.
Food science
The quality of cereal flours and the hardness of dough are affected by their xylan content,[6] thus, playing a significant role in bread industry. The main constituent of xylan can be converted into xylitol (a xylose derivative), which is used as a natural food sweetener, which helps to reduce dental cavities and acts as a sugar substitute for diabetic patients. Poultry feed has a high percentage of xylan.[6]
Xylan is one of the foremost anti-nutritional factors in common use feedstuff raw materials. Xylooligosaccharides produced from xylan are considered as "functional food" or dietary fibers[13] due their potential prebiotic properties.[14]
Crystallinity
The regular branching patterns of xylans may facilitate their co-crystallization with cellulose in the plant cell wall.[15] Xylan also tends to crystallize from aqueous solution.[16] Additional polymorphs of (1→4)-β-D-xylan have been obtained by crystallization from non-aqueous environments.[17]
Biosynthesis
Several glycosyltransferases are involved in the biosynthesis of xylans.[18][19]
In eukaryotes, GTs represent about 1% to 2% of gene products.[20] GTs are assembled into complexes existing in the Golgi apparatus. However, no xylan synthase complexes have been isolated from Arabidopsis tissues (dicot). The first gene involved in the biosynthesis of xylan was revealed on xylem mutants (irx) in Arabidopsis thaliana because of some mutation affecting xylan biosynthesis genes. As a result, abnormal plant growth due to thinning and weakening of secondary xylem cell walls was seen.[21] Arabidopsis mutant irx9 (At2g37090), irx14 (At4g36890), irx10/gut2 (At1g27440), irx10-L/gut1 (At5g61840) showed defect in xylan backbone biosynthesis.[21] Arabidopsis mutants irx7, irx8, and parvus are thought to be related to the reducing end oligosaccharide biosynthesis.[22] Thus, many genes have been associated with xylan biosynthesis but their biochemical mechanism is still unknown. Zeng et al. (2010) immuno-purified xylan synthase activity from etiolated wheat (Triticum aestivum) microsomes.[23] Jiang et al. (2016) reported a xylan synthase complex (XSC) from wheat that has a central core formed of two members of the GT43 and GT47 families (CAZy database). They purified xylan synthase activity from wheat seedlings through proteomics analysis and showed that two members of TaGT43 and TaGT47 are sufficient for the synthesis of a xylan-like polymer in vitro.[24]
Breakdown
Xylanase converts xylan into xylose. Given that plants contain up to 30% xylan, xylanase is important to the nutrient cycle.[25] The degradation of xylan and other hemicelluloses is relevant to the production of biofuels. Being less crystalline and more highly branched, these hemicelluloses are particularly susceptible to hydrolysis.[26][27]
Research
As a major component of plants, xylan is potentially a significant source of renewable energy especially for second generation biofuels.[28] However, xylose (backbone of xylan) is a pentose sugar that is hard to ferment during biofuel conversion because microorganisms like yeast cannot ferment pentose naturally.[29]
References
- ↑ Horst H. Nimz, Uwe Schmitt, Eckart Schwab, Otto Wittmann, Franz Wolf "Wood" in Ullmann's Encyclopedia of Industrial Chemistry 2005, Wiley-VCH, Weinheim. doi:10.1002/14356007.a28_305
- ↑ Carpita, Nicholas C. (2011-01-01). "Update on Mechanisms of Plant Cell Wall Biosynthesis: How Plants Make Cellulose and Other (1→4)-β-d-Glycans". Plant Physiology. 155 (1): 171–184. doi:10.1104/pp.110.163360. ISSN 0032-0889. PMC 3075763. PMID 21051553.
- ↑ Collins English Dictionary
- ↑ Houghton Mifflin Harcourt, The American Heritage Dictionary of the English Language, Houghton Mifflin Harcourt.
- ↑ Mellerowicz, E. J.; Gorshkova, T. A. (2011-11-16). "Tensional stress generation in gelatinous fibres: a review and possible mechanism based on cell-wall structure and composition". Journal of Experimental Botany. 63 (2): 551–565. doi:10.1093/jxb/err339. ISSN 0022-0957. PMID 22090441.
- 1 2 3 Faik, Ahmed (2010-06-01). "Xylan Biosynthesis: News from the Grass". Plant Physiology. 153 (2): 396–402. doi:10.1104/pp.110.154237. ISSN 0032-0889. PMC 2879768. PMID 20375115.
- ↑ Balakshin, Mikhail; Capanema, Ewellyn; Gracz, Hanna; Chang, Hou-min; Jameel, Hasan (2011-02-05). "Quantification of lignin–carbohydrate linkages with high-resolution NMR spectroscopy". Planta. 233 (6): 1097–1110. Bibcode:2011Plant.233.1097B. doi:10.1007/s00425-011-1359-2. ISSN 0032-0935. PMID 21298285. S2CID 13080720.
- ↑ De Oliveira, Dyoni Matias; Finger-Teixeira, Aline; Rodrigues Mota, Thatiane; Salvador, Victor Hugo; Moreira-Vilar, Flávia Carolina; Correa Molinari, Hugo Bruno; Craig Mitchell, Rowan Andrew; Marchiosi, Rogério; Ferrarese-Filho, Osvaldo; Dantas Dos Santos, Wanderley (2015). "Ferulic acid: A Key Component in Grass Lignocellulose Recalcitrance to Hydrolysis" (PDF). Plant Biotechnology Journal. 13 (9): 1224–1232. doi:10.1111/pbi.12292. PMID 25417596. S2CID 6171914.
- ↑ Faik, Ahmed (2013), "Plant Cell Wall Structure-Pretreatment" the Critical Relationship in Biomass Conversion to Fermentable Sugars, SpringerBriefs in Molecular Science, Springer Netherlands, pp. 1–30, doi:10.1007/978-94-007-6052-3_1, ISBN 9789400760516
- ↑ Sixta, Herbert, ed. (2006). Handbook of pulp. Vol. 1. Weinheim, Germany: Wiley-VCH Verlag GmbH & Co. KGaA. pp. 28–30. ISBN 978-3-527-30999-3.
- ↑ Ebringerová, Anna; Hromádková, Zdenka; Heinze, Thomas (2005-01-01). Heinze, Thomas (ed.). Hemicellulose. Advances in Polymer Science. Springer Berlin Heidelberg. pp. 1–67. doi:10.1007/b136816. ISBN 9783540261124.
- ↑ "Xylan Glycoproducts for life sciences - Engineering and production". www.elicityl-oligotech.com. Retrieved 2016-04-20.
- ↑ Alonso JL, Dominguez H, Garrote G, Parajo JC, Vazques MJ (2003). "Xylooligosaccharides: properties and production technologies". Electron. J. Environ. Agric. Food Chem. 2 (1): 230–232.
- ↑ Broekaert, W.F.; Courtin, C.M.; Verbeke, C.; Van de Wiele, T.; Verstraete, W.; Delcour, J.A (2011). "Prebiotic and Other Health-Related Effects of Cereal-Derived Arabinoxylans, Arabinoxylan-Oligosaccharides, and Xylooligosaccharides". Critical Reviews in Food Science and Nutrition. 51 (2): 178–194. doi:10.1080/10408390903044768. PMID 21328111. S2CID 205689400.
- ↑ Simmons, Thomas J.; Mortimer, Jenny C.; Bernardinelli, Oigres D.; Pöppler, Ann-Christin; Brown, Steven P.; deAzevedo, Eduardo R.; Dupree, Ray; Dupree, Paul (December 2016). "Folding of xylan onto cellulose fibrils in plant cell walls revealed by solid-state NMR". Nature Communications. 7 (1): 13902. Bibcode:2016NatCo...713902S. doi:10.1038/ncomms13902. ISSN 2041-1723. PMC 5187587. PMID 28000667.
- ↑ Smith, Peter J.; Curry, Thomas M.; Yang, Jeong-Yeh; Barnes, William J.; Ziegler, Samantha J.; Mittal, Ashutosh; Moremen, Kelley W.; York, William S.; Bomble, Yannick J.; Peña, Maria J.; Urbanowicz, Breeanna R. (2022-07-13). "Enzymatic Synthesis of Xylan Microparticles with Tunable Morphologies". ACS Materials Au. 2 (4): 440–452. doi:10.1021/acsmaterialsau.2c00006. ISSN 2694-2461. PMC 9284610. PMID 35856073.
- ↑ Meng, Zhuojun; Sawada, Daisuke; Laine, Christiane; Ogawa, Yu; Virtanen, Tommi; Nishiyama, Yoshiharu; Tammelin, Tekla; Kontturi, Eero (2021-02-08). "Bottom-up Construction of Xylan Nanocrystals in Dimethyl Sulfoxide". Biomacromolecules. 22 (2): 898–906. doi:10.1021/acs.biomac.0c01600. ISSN 1525-7797. PMID 33410657. S2CID 230818554.
- ↑ Pauly, Markus; Gille, Sascha; Liu, Lifeng; Mansoori, Nasim; De Souza, Amancio; Schultink, Alex; Xiong, Guangyan (2013). "Hemicellulose biosynthesis". Planta. 238 (4): 627–642. Bibcode:2013Plant.238..627P. doi:10.1007/s00425-013-1921-1. PMID 23801299. S2CID 17501948.
- ↑ Zhong, Ruiqin; Ye, Zheng-Hua (2015). "Secondary Cell Walls: Biosynthesis, Patterned Deposition and Transcriptional Regulation". Plant and Cell Physiology. 56 (2): 195–214. doi:10.1093/pcp/pcu140. PMID 25294860.
- ↑ Lairson, L.L.; Henrissat, B.; Davies, G.J.; Withers, S.G. (2008-06-02). "Glycosyltransferases: Structures, Functions, and Mechanisms". Annual Review of Biochemistry. 77 (1): 521–555. doi:10.1146/annurev.biochem.76.061005.092322. ISSN 0066-4154. PMID 18518825.
- 1 2 Wu, Ai-Min; Hörnblad, Emma; Voxeur, Aline; Gerber, Lorenz; Rihouey, Christophe; Lerouge, Patrice; Marchant, Alan (2010-06-01). "Analysis of the Arabidopsis IRX9/IRX9-L and IRX14/IRX14-L Pairs of Glycosyltransferase Genes Reveals Critical Contributions to Biosynthesis of the Hemicellulose Glucuronoxylan". Plant Physiology. 153 (2): 542–554. doi:10.1104/pp.110.154971. ISSN 0032-0889. PMC 2879767. PMID 20424005.
- ↑ Peña, Maria J.; Zhong, Ruiqin; Zhou, Gong-Ke; Richardson, Elizabeth A.; O'Neill, Malcolm A.; Darvill, Alan G.; York, William S.; Ye, Zheng-Hua (2007-02-01). "Arabidopsis irregular xylem8 and irregular xylem9: Implications for the Complexity of Glucuronoxylan Biosynthesis". The Plant Cell. 19 (2): 549–563. Bibcode:2007PlanC..19..549P. doi:10.1105/tpc.106.049320. ISSN 1040-4651. PMC 1867335. PMID 17322407.
- ↑ Zeng, Wei; Chatterjee, Mohor; Faik, Ahmed (2008-05-01). "UDP-Xylose-Stimulated Glucuronyltransferase Activity in Wheat Microsomal Membranes: Characterization and Role in Glucurono(arabino)xylan Biosynthesis". Plant Physiology. 147 (1): 78–91. doi:10.1104/pp.107.115576. ISSN 0032-0889. PMC 2330321. PMID 18359844.
- ↑ Jiang, Nan; Wiemels, Richard E.; Soya, Aaron; Whitley, Rebekah; Held, Michael; Faik, Ahmed (2016-04-01). "Composition, Assembly, and Trafficking of a Wheat Xylan Synthase Complex". Plant Physiology. 170 (4): 1999–2023. doi:10.1104/pp.15.01777. ISSN 0032-0889. PMC 4825154. PMID 26917684.
- ↑ Juturu, Veeresh; Wu, Jin Chuan (2012). "Microbial xylanases: Engineering, production and industrial applications". Biotechnology Advances. 30 (6): 1219–1227. doi:10.1016/j.biotechadv.2011.11.006. PMID 22138412.
- ↑ Chiaramonti, David; Prussi, Matteo; Ferrero, Simone; Oriani, Luis; Ottonello, Piero; Torre, Paolo; Cherchi, Francesco (2012). "Review of pretreatment processes for lignocellulosic ethanol production, and development of an innovative method". Biomass and Bioenergy. 46: 25–35. Bibcode:2012BmBe...46...25C. doi:10.1016/j.biombioe.2012.04.020.
- ↑ Carvalho, Ana Flávia Azevedo; Neto, Pedro de Oliva; Da Silva, Douglas Fernandes; Pastore, Gláucia Maria (2013). "Xylo-oligosaccharides from lignocellulosic materials: Chemical structure, health benefits and production by chemical and enzymatic hydrolysis". Food Research International. 51: 75–85. doi:10.1016/j.foodres.2012.11.021.
- ↑ Johnson, Kim L.; Gidley, Michael J.; Bacic, Antony; Doblin, Monika S. (2018). "Cell wall biomechanics: a tractable challenge in manipulating plant cell walls 'fit for purpose'!". Current Opinion in Biotechnology. 49: 163–171. doi:10.1016/j.copbio.2017.08.013. ISSN 0958-1669. PMID 28915438.
- ↑ Rennie, Emilie A.; Scheller, Henrik Vibe (2014-04-01). "Xylan biosynthesis". Current Opinion in Biotechnology. 26: 100–107. doi:10.1016/j.copbio.2013.11.013. ISSN 0958-1669. PMID 24679265.